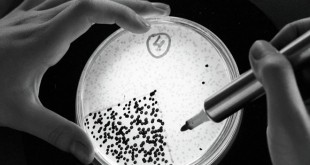

واشنطن-سانا عثر فريق من الباحثين الأمريكيين على حيوان برمائي نادر في جداول المياه الموحلة
المزيدطرائف وغرائب
علماء يابانيون يطورون مادة بلاستيكية تقلل التلوث وتذوب بمياه البحر خلال ساعتين
طوكيو-سانا طور باحثون من معهد “ريكن” وجامعة طوكيو في اليابان مادة بلاستيكية تذوب تماماً في مياه البحر خلال ساعتين فقط
المزيدفي طريق رحلتها جنوباً… أسراب اللقلق الأبيض تشكل لوحات جميلية في سماء دمشق
دمشق-سانا غطت أسراب من طائر اللقلق الأبيض سماء دمشق بأعداد كبيرة صباح اليوم في رحلتها السنوية جنوبا مشكلة في تحركاتها لوحات وأشكالاً جميلة متعددة. واللقلق الأبيض أو “أبو سعد” كما يسميه الناس في بلاد الشام من الطيور الخواضة ذات الأرجل …
المزيدزلزال بقوة 8ر6 درجات يضرب جزر سليمان
سيدني-سانا ضرب زلزال بقوة 8ر6 درجات مساء أمس جزر سليمان في المحيط الهادىء إلا أنه لم يعلن عن أي انذار بوجود مد بحري. ونقلت ا ف ب عن المعهد الأميركي للجيولوجيا قوله إن الزلزال وقع على عمق 01ر28 كلم وعلى …
المزيدعلماء روس يكتشفون كائنات مجهرية تجدد الشباب
موسكو-سانا عثر علماء البيولوجيا الروس في رفات حيوان الماموث المتجمد على كائنات حية مجهرية يمكنها تجديد الشباب. ونقلت وكالة سبوتنيك الروسية عن الطبيب الروسي فيكتور تشيرنيافسكي قوله إن” علماء البيولوجيا أصبحوا قاب قوسين أو أدنى من التوصل إلى اكسير الشباب …
المزيدغبار المنزل يحوي 9 آلاف نوع من الجراثيم
الولايات المتحدة-سانا كشفت دراسة أميركية أن الغبار الموجود في المنازل يحتوي “في المتوسط” على 9000 نوع مختلف من الجراثيم. وقد عمل باحثون من جامعة كولورادو الأميركية على تحليل الغبار الذي وجد في 1200 منزل عبر مناطق الولايات المتحدة، إذ اكتشفوا …
المزيدجدة تعيش مراهقتها على انستغرام
ناشفيل-سانا قد تكون هيلين فان وينكل من تينيسي أروع جدة على موقع التواصل الاجتماعي انستغرام إذ أن البالغة من العمر 87 عاما تتمتع بشخصية شبابية فريدة من نوعها. وتواكب فان وينكل أجدد صيحات الموضة مسمية نفسها على الانستغرام “Baddie Winkle” …
المزيدتلفزيون هنغاري يطرد مصورة ركلت مهاجرين أثناء فرارهم من الشرطة
بودابست-سانا طردت قناة تلفزيونية هنغارية خاصة إحدى مصوراتها بعدما ظهرت وهي تركل وتوقع مهاجرين بمن فيهم أطفال على الأرض أثناء محاولتهم الفرار من طوق أمني في روزكي جنوب البلاد. ونقلت وكالة الصحافة الفرنسية عن سابولكس كيسبيرك رئيس تحرير قناة “ان1تي …
المزيدوفاة أقصر إنسان في العالم عن عمر ناهز 76 عاما
نيودلهي-سانا فارق النيبالي شاندرا بهادور دانغي الذي كان أقصر رجل على كوكب الأرض الحياة عن عمر ناهز 76 عاما، حسبما أفادت صحيفة “كاتماندو بوست” الهندية. وكتبت الصحيفة أن النيبالي توفي في إحدى جزر بأرخبيل ساموا في المحيط الهادئ الخميس الماضي …
المزيدآخر مائدة طعام على متن تايتانيك في مزاد علني بـ 70 ألف دولار
موسكو-سانا تجري التحضيرات لطرح آخر مائدة طعام كانت على متن سفينة تايتانيك في مزاد على الانترنت مع توقعات ببيعها بنحو 70 ألف دولار. وذكر موقع روسيا اليوم أن مائدة الطعام ستباع في الـ 30 أيلول الجاري على موقع مزادات إنفاليوبل …
المزيد S A N A الوكالة العربية السورية للأنباء
S A N A الوكالة العربية السورية للأنباء